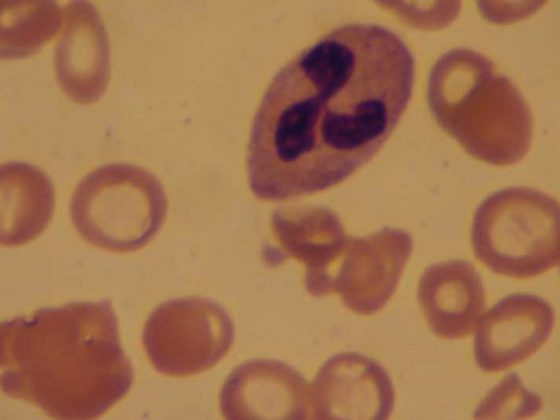

La depressione spesso non viene individuata nei pazienti anziani, perché i sintomi depressivi tipici passano in secondo piano rispetto ai sintomi fisici. La depressione non è una conseguenza normale dell’invecchiamento, ma può avere un impatto negativo duraturo su di esso e renderlo più difficile. Il trattamento della depressione è promettente anche negli anziani, ma deve considerare attentamente la loro particolare vulnerabilità (prestazioni cognitive, comorbilità fisica, politerapia). Per la depressione lieve, gli interventi psicoterapeutici possono essere sufficienti. Per la depressione più grave, di solito è indicata una combinazione con i farmaci. Per la farmacoterapia, gli SSRI sono la prima scelta. Questi – così come altri possibili antidepressivi – devono essere dosati secondo il principio “iniziare con poco, andare piano”, in base all’efficacia e alla tollerabilità. Un farmaco antidepressivo efficace deve essere mantenuto a dosaggio invariato per un periodo di tempo più lungo – diversi mesi – per evitare ricadute.
La prevalenza puntuale degli episodi depressivi maggiori negli anziani varia tra il 5 e il 10%, quella degli episodi lievi o moderati tra il 5 e il 35%. La grande variabilità è dovuta, tra l’altro, alle diverse popolazioni. Ad esempio, la prevalenza della depressione è da 10 a 20 volte più bassa tra gli anziani indipendenti integrati nella comunità rispetto alle case di riposo e alle case di cura [1]. A contribuire ai bassi tassi di prevalenza possono essere l’accettazione a volte limitata della diagnosi e l’apparente malinteso che la depressione sia una normale conseguenza dell’età.
Rispetto ai depressi più giovani, le differenze principali risiedono nell’interazione tra la depressione e l’invecchiamento del corpo, vale a dire le comorbidità somatiche e psicologiche che la accompagnano o la conseguente polifarmacia. I fattori biologici, sociali e psicologici associati all’età influenzano la diagnosi e la terapia. L’invecchiamento può essere accompagnato da drastici cambiamenti sociali, ad esempio la perdita di un coniuge o un trasferimento a causa di una malattia. Tali cambiamenti possono favorire lo sviluppo della depressione nelle persone vulnerabili.
Interazioni tra depressione e malattie somatiche
La depressione può essere sia un fattore di rischio che una conseguenza delle malattie somatiche. Tali interazioni compromettono la prognosi e aumentano la mortalità della depressione e della malattia fisica (Tab. 1). Queste interazioni esistono, ad esempio, tra la depressione e l’insufficienza renale cronica, la broncopneumopatia cronica ostruttiva e le malattie cerebrovascolari o cardiovascolari [2]. Una buona terapia antidepressiva può ridurre al minimo le interazioni sfavorevoli.

Le connessioni tra depressione e demenza sono molteplici. Ci sono prove che la depressione all’inizio della vita è un fattore di rischio potenziale per la demenza associata all’età [3]. Inoltre, la depressione può essere un prodromo della demenza, soprattutto se il primo episodio depressivo si verifica dopo i 60 anni. Infine, la depressione si manifesta anche nel corso della demenza, che può portare a ulteriori perdite nella cognizione o nelle funzioni quotidiane. Nei pazienti affetti da demenza, la distinzione clinica tra depressione e apatia è spesso difficile: a volte solo un tentativo di terapia pragmatica con un antidepressivo aiuta in questo caso.
Il deterioramento cognitivo si riscontra nel 30-40% degli anziani con depressione. Sono tipici i deficit di attenzione, l’alterazione della velocità di elaborazione e delle funzioni esecutive. Una grave disfunzione esecutiva nel contesto della depressione è spesso associata a una prognosi peggiore [4]. Il più delle volte, i profili delle prestazioni cognitive dei depressi non sono molto informativi rispetto alla popolazione normale, perché la cognizione è compromessa in modo non specifico. Molti depressi hanno grandi difficoltà a lavorare con motivazione e concentrazione durante un test cognitivo. Si arrendono rapidamente nella situazione di prova o si esprimono in modo nichilista. Questo deve essere preso in considerazione quando si interpretano i risultati cognitivi. Tuttavia, un esame di screening cognitivo all’inizio della terapia antidepressiva aiuta a valutare il decorso e a distinguere tra depressione e demenza.
Fisiopatologia della depressione in età avanzata
Anche i disturbi associati allo stress e i loro effetti sulla regolazione dell’asse ipotalamo-ipofisi-surrene svolgono un ruolo nella genesi della depressione in età avanzata. Inoltre, l’imaging funzionale e strutturale mostra cambiamenti nel cervello frontale e nella sua connessione con il sistema limbico o striatale. Si tratta in genere di cambiamenti atrofici nella materia grigia o di cambiamenti microvascolari nella materia bianca, alcuni dei quali si correlano con la gravità dei sintomi clinici, ad esempio la gravità della disfunzione esecutiva [4]. La relazione tra i cambiamenti vascolari e la depressione è complessa e non è stata compresa in modo definitivo.
Presentazione clinica della depressione in età avanzata
I criteri di depressione dell’ICD-10 non tengono conto dell’età. I pazienti anziani hanno meno probabilità di riferire lo sconforto e sono più propensi a riferire sintomi fisici come problemi digestivi, dolore, disturbi del sonno o affaticamento (Tabella 2) . Altri si distinguono per il loro comportamento burbero e scontroso. Il deterioramento cognitivo e gli stati di agitazione sono più comuni negli anziani che nei pazienti più giovani. Soprattutto nei pazienti anziani, la depressione è uno dei fattori di rischio di suicidio: i tentativi di suicidio sono piuttosto rari negli anziani, ma i suicidi completati sono più frequenti, soprattutto negli uomini. I cambiamenti fisici e sociali possono favorire la disperazione e il suicidio [5].

Diagnostica
L’anamnesi (eventualmente integrata da un’anamnesi esterna) è di particolare importanza nella diagnosi, con la quale si chiedono i disturbi iniziali, la loro evoluzione e i disturbi attuali. L’anamnesi consente di valutare il decorso della malattia (unipolare vs. bipolare o primo episodio vs. decorso ricorrente). Nell’anamnesi vengono chiesti i rischi, in particolare la suicidalità, le comorbidità mediche e psichiatriche, l’abuso di sostanze (benzodiazepine o alcol) e i farmaci attuali.
La “Scala di depressione geriatrica a 15 voci” può essere utilizzata come strumento di screening per la depressione [6]. Poiché molti malati hanno fluttuazioni diurne, la depressione può essere più difficile da cogliere durante un’esplorazione serale. Pertanto, sono utili gli esami di follow-up.
L’anamnesi medica è integrata da uno stato somatico e psichico e da uno screening cognitivo, ad esempio con il Mini Mental Status (MMS) [7] o il Montreal Cognitive Assessment (MOCA) [8]. L’MMS è meno bravo a quantificare la disfunzione esecutiva rispetto al MOCA. Gli esami di laboratorio aiutano a identificare le comorbilità somatiche (Fig. 1).

Principi del trattamento antidepressivo
Il trattamento della depressione negli anziani è troppo complesso per essere riprodotto in modo esaustivo in questa sede. Attualmente, un gruppo di esperti in Svizzera sta sviluppando nuove linee guida basate sull’evidenza per la diagnosi e il trattamento della depressione in età avanzata. A questo punto, vengono riassunti solo alcuni punti essenziali del trattamento.
Anche negli anziani, la combinazione di terapia psicofarmacologica e psicoterapeutica è di efficacia superiore nel trattamento acuto della depressione da moderata a grave. Per la depressione lieve, la psicoterapia può essere superiore alla farmacoterapia. In riferimento all’età e ai deficit cognitivi, gli interventi psicoterapeutici sono utilizzati con troppa cautela, anche se sono certamente disponibili adattamenti metodologici in questo senso. Gli studi hanno dimostrato l’efficacia degli interventi di revisione della vita o di problem-solving.
Gli antidepressivi sono efficaci nella terza età, anche se ci si deve aspettare una resistenza un po’ più elevata alla terapia. La gestione dei farmaci può essere complicata dalle interazioni con le comorbidità fisiche, gli effetti collaterali o le interazioni farmacologiche dovute alla politerapia o alle alterazioni della farmacocinetica e della dinamica. Prima di iniziare una nuova terapia antidepressiva, l’attuale terapia farmacologica deve essere attentamente rivista, al fine di ridurre al minimo il numero di farmaci e le interazioni e di escludere gli stati depressivi coindotti dai farmaci.
Nel trattamento acuto, vengono spesso utilizzati gli inibitori selettivi della ricaptazione della serotonina (SSRI) o gli antidepressivi con doppio effetto (serotoninergico e noradrenergico) (SNRI). Entrambi i gruppi sono considerati di prima scelta perché sono ben tollerati. Tuttavia, con le sostanze noradrenergiche, tra l’altro, si deve tenere conto del possibile aumento della pressione sanguigna come effetto collaterale. È possibile che le sindromi di inadeguata secrezione di ADH (SIADH) e i conseguenti disturbi elettrolitici si verifichino più frequentemente negli anziani che nei pazienti più giovani. I classici antidepressivi triciclici non sono la terapia di prima scelta a causa degli effetti collaterali anticolinergici (difficoltà di minzione, costipazione, disregolazione ortostatica, accentuazione dei deficit cognitivi).
Una causa frequente della mancanza di remissione è il dosaggio riluttante della terapia antidepressiva. La dose iniziale di antidepressivo raccomandata per gli anziani è spesso inferiore a quella dei pazienti più giovani (nel senso di “iniziare con poco, andare piano”), ma il dosaggio deve essere aumentato con attenzione se ben tollerato e se i sintomi persistono, prima di prendere in considerazione alternative come il cambio, l’aumento o le terapie combinate. La durata della terapia antidepressiva non può essere determinata all’inizio della terapia. Se il paziente tollera bene l’antidepressivo, deve continuare con la stessa dose durante la remissione (“la dose che fa stare bene, fa stare bene”).
Negli anziani, il tasso di ricaduta è elevato e il rischio di ricaduta aumenta quando la dose viene ridotta o il farmaco viene interrotto. Gli studi a lungo termine indicano che le terapie di mantenimento sono efficaci per tre anni dopo la remissione [9].
La profilassi con litio è efficace per il disturbo bipolare anche in età avanzata. Studi a lungo termine dimostrano che i disturbi bipolari non diventano asintomatici in età avanzata. Purtroppo non esistono raccomandazioni su quando interrompere la profilassi con il litio nell’insufficienza renale cronica. Alcuni pazienti con disturbo bipolare sviluppano gravi ricadute dopo l’interruzione della profilassi, per cui è opportuna un’analisi molto attenta dei rischi e dei benefici quando si prende questa decisione.
In un ampio studio, non sono state riscontrate differenze tra il trattamento con verum e placebo dei pazienti affetti da demenza con depressione con sertralina e mirtazapina [10]. Tuttavia, non si può concludere da questi risultati che la depressione non debba essere trattata nel contesto della demenza, poiché gli studi mostrano effetti antidepressivi in tutti i trattamenti e la depressione nei pazienti affetti da demenza è associata a una riduzione della qualità di vita o a un’accentuazione delle menomazioni.
Letteratura:
- Chapman DP, Perry GS: La depressione come componente principale della salute pubblica per gli adulti anziani. Prev Chronic Dis 2008; 5(1): 1-9.
- Teply RM, et al: Trattamento della depressione nei pazienti con malattia cardiaca concomitante. Prog Cardiovasc Dis 2015 pii: S0033-0620(15)30022-0 [Epub ahead of print].
- Diniz BS, et al: Depressione in tarda età e rischio di demenza vascolare e malattia di Alzheimer: revisione sistematica e meta-analisi di studi di coorte basati sulla comunità. Br J Psychiatry 2013; 202(5): 329-335.
- Baldwin R, et al: Risposta al trattamento nella depressione ad esordio tardivo: relazione con i fattori di rischio neuropsicologici, neuroradiologici e vascolari. Psychol Med 2004; 34(1): 125-136.
- Minder J, Harbauer G: Suicidio in età avanzata. Archivio svizzero di neurologia e psichiatria 2015; 166(3): 67-77.
- Sheikh JI, Yesavage JA: Scala di depressione geriatrica (GDS): prove recenti e sviluppo di una versione più breve. In Gerontologia clinica: Guida alla valutazione e all’intervento, ed. TL Brink, pp. 165-73. New York: The Haworth Press, 1986.
- Folstein MF, et al: Mini-Mental State (un metodo pratico per valutare lo stato dei pazienti per il medico). Journal of Psychiatric Research 1975; 12: 189-198.
- Nasreddine ZS, et al: Il Montreal Cognitive Assessment, MoCA: uno strumento di screening breve per il deterioramento cognitivo lieve. JAGS 2005; 53: 695-699.
- Reynolds CF 3rd, et al: Trattamento di mantenimento della depressione maggiore in età avanzata. N Engl J Med 2006; 354(11): 1130-1138.
- Banerjee S, et al: Sertralina o mirtazapina per la depressione nella demenza (HTA-SADD): uno studio randomizzato, multicentrico, in doppio cieco, controllato con placebo. Lancet 2011; 378(9789): 403-411.
InFo NEUROLOGIA & PSICHIATRIA 2016; 14(3). 28-30